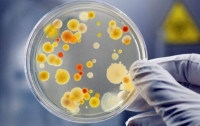
Боевиков на Донбассе косит эпидемия кори

ВСЕ НОВОСТИ
-
 21:32 Здоровье
21:32 Здоровье
Эпидемия кори: новая вспышка зафиксирована в Тернопольской области
-
 18:36 Здоровье
18:36 Здоровье
Уровень заболеваемости корью в Украине снижается, - МОЗ
-
 21:39 Киев
21:39 Киев
Корь в Киеве: зафиксировано 200 случаев заболевания
-
 22:49 Здоровье
22:49 Здоровье
Вспышка кори в Запорожье: зарегистрированы новые случаи
-
20:04 Здоровье
20:04 Здоровье
Боевиков на Донбассе косит эпидемия кори
-
 18:24 Здоровье
18:24 Здоровье
Эпидемия гриппа свирепствует в четырех областях Украины
-
 20:04 Мир
20:04 Мир
Эпидемия гриппа в Чехии: погибли 50 человек
-
 21:54 Здоровье
21:54 Здоровье
Смертность от кори за два месяца 2018 уже превысила показатели 2017
-
 21:32 Здоровье
21:32 Здоровье
Грипп и ОРВИ в Украине: в пяти областях превышен эпидемический порог
-
 16:57 Харьков
16:57 Харьков
Грипп и ОРВИ в Харьковской области: школьники сидят дома
-
 20:03 Здоровье
20:03 Здоровье
Пик заболевания корью в Украине уже прошел, - МОЗ
-
 22:26 Здоровье
22:26 Здоровье
Корь в Европе: Украина – в тройке лидеров по количеству больных
-
 21:20 Киев
21:20 Киев
205 киевских школ остаются закрытыми на карантин
-
 18:02 Здоровье
18:02 Здоровье
Грипп продолжает атаку: заболели 12 тысяч жителей Прикарпатья
-
 17:19 Здоровье
17:19 Здоровье
В пяти областях Украины объявлена эпидемия гриппа




